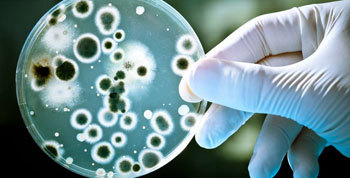
3-2

Новини
На підвищення прожиткового мінімуму немає грошей
За офіційними розрахунками, підлітку в Україні належить одна зимова куртка на три роки і одна демісезонна теж на три. А жінці дві сукні чи костюми на сім років.
Про це заявив голова фінансового комітету Верховної Ради Данило Гетьманцев в ефірі «Новини. Live», обговорюючи норми прожиткового мінімуму в Україні.
Детальніше: На підвищення прожиткового мінімуму немає грошей
МВФ вимагає підвищити тарифи на комуналку
Україні після війни слід підвищити тарифи на комунальні послуги. Про це йдеться у новому меморандумі Міжнародного валютного фонду (МВФ).
У документі сказано, що незважаючи на підвищення у 2023-2024 роках, «ціни на електроенергію для населення становлять близько половини рівня цін для малого бізнесу, тоді як ціни на газ для населення покривають приблизно 50% витрат на основі ринкових цін на газ».
До кінця року Євросоюз поставить Україні два мільйони снарядів
Євросоюз до кінця поточного року передасть Україні два мільйони снарядів та 1,5 мільярда євро. Для цього буде використано російські гроші.
Про це під час брифінгу у Копенгагені повідомила голова Європейської комісії Урсула фон дер Ляєн.
- Фактично росія оплачує ту зброю, яку використовуватиме Україна, - сказала вона.
Детальніше: До кінця року Євросоюз поставить Україні два мільйони снарядів
Україна та росія провели черговий обмін полоненими
Відбувся черговий обмін полоненими між Україною та росією. З російського полону повернулися захисники, які воювали на різних напрямках, а також цивільні. Більшість із них перебувала в російському полоні ще з 2022 року. Про це повідомив Володимир Зеленський.
Президент зазначив, що обміни мають тривати, і подякував всім, хто це забезпечує. Він сказав, що мета України звільнити всіх наших людей із російського полону.
Детальніше: Україна та росія провели черговий обмін полоненими
У криворізьких водоймах виявили бактерії
У Кривому Розі, Самарі та на Нікопольщині у трьох пробах прісної води виявлено неепідемічний штам холерного вібріона не О1 групи. Цей штам не викликає захворювання на холеру, проте може спричиняти гострі кишкові інфекції. Про це повідомляє ДУ «Дніпропетровський обласний центр контролю та профілактики хвороб МОЗ України».
У Кривому Розі, Самарі та на Нікопольщині у трьох пробах прісної води виявлено неепідемічний штам холерного вібріона не О1 групи. Цей штам не викликає захворювання на холеру, проте може спричиняти гострі кишкові інфекції. Про це повідомляє ДУ «Дніпропетровський обласний центр контролю та профілактики хвороб МОЗ України».
У Кривому Розі штам неепідемічного холерного вібріона було виявлено в водоймі в житловому масиві Південного ГЗК (балка Іванівська).





